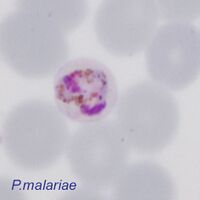

Navegación
>Índice principal de Malaria
>>Índice de Biología de la Malaria
>>>Página actual: Biología del trofozoíto
La biología de la etapa del trofozoíto
|
El punto de partida
Todos los parásitos de la malaria aparecen como "formas de anillo" cuando ingresan por primera vez en el glóbulo rojo. Inicialmente, todas las especies comparten las mismas características y son muy difíciles de distinguir. La imagen de un anillo se muestra a continuación, con un punto de cromatina oscura (Chr), que ocasionalmente puede ser doble, citoplasma pálido azul (Cyt) y una vacuola central (Vac).
Sin embargo, durante la etapa del trofozoíto, el parásito se desarrolla progresivamente hasta convertirse en un esquizonte o un gametocito. Esto requiere numerosos cambios, algunos de los cuales difieren entre especies y se utilizan como características para diferenciarlas (ver descripciones a continuación).
Alimentación
El desarrollo del parásito requiere energía y proteínas, que obtiene del metabolismo de la hemoglobina. Este proceso ocurre en todas las etapas, pero sus efectos se vuelven evidentes en la fase tardía del trofozoíto. Durante esta fase, pueden observarse dos cambios: primero, el glóbulo rojo cambia de color en comparación con los glóbulos normales, ya que el parásito metaboliza la globina (proteína) de la hemoglobina. Como resultado, las células comienzan a perder pigmento de hemoglobina y se vuelven más pálidas en una preparación teñida adecuadamente. En segundo lugar, la desintoxicación del grupo hemo de la hemoglobina da lugar a la formación de hemozoína, que puede observarse como pigmento de malaria.
Estos cambios pueden no ser evidentes en la etapa temprana del trofozoíto y varían entre especies, pero generalmente se detectan en la fase tardía del trofozoíto (como se muestra en la imagen de un trofozoíto tardío de P. malariae).
Comunicación, nutrición y evasión inmune
Los parásitos no son simplemente pasajeros pasivos dentro de los glóbulos rojos. Necesitan nutrición y la eliminación de toxinas, además de modificar la célula huésped para evitar la destrucción por el sistema inmunológico. Para ello, alteran el eritrocito de diversas maneras. Muchos de estos cambios no son visibles con microscopía estándar, pero la formación de estructuras puntiformes representa una de estas modificaciones. Diferentes tipos de puntos citoplasmáticos pueden observarse en todas las especies en distintos grados, dependiendo de la tinción utilizada. Los más conocidos son los puntos de Schüffner o de James en P. vivax y P. ovale, así como los puntos y hendiduras de Maurer en P. falciparum. Las imágenes a continuación muestran los puntos rosados/morados de Schüffner en P. vivax y los puntos de Maurer en P. falciparum.
Citoesqueleto y adhesión
Otra modificación del glóbulo rojo afecta su citoesqueleto. Como en otros casos, los cambios varían entre especies. Aunque la función exacta de estos cambios no está completamente clara en cada caso, se sabe que los glóbulos rojos infectados tienen diferentes propiedades de adhesión en comparación con los no infectados. Esto puede influir en su interacción con el sistema inmunológico o permitir su secuestro en compartimentos específicos de la circulación. Las modificaciones en el tamaño y forma del glóbulo rojo se describen en secciones separadas y también en las páginas de reconocimiento de especies. Dos características distintivas son el agrandamiento irregular de los eritrocitos en P. vivax y la reducción del tamaño del eritrocito en P. malariae, que se muestran a continuación.
|